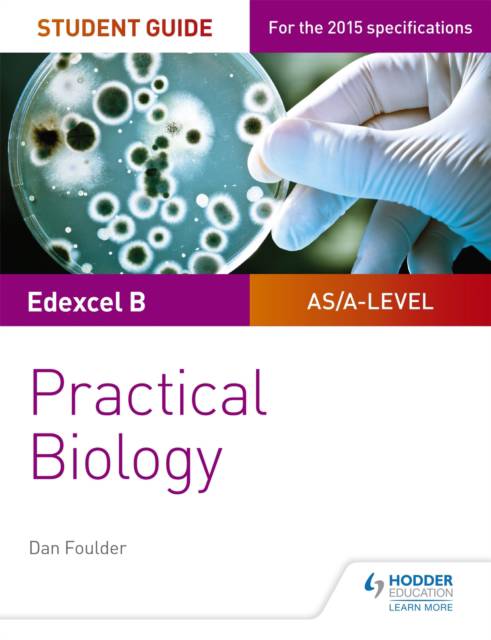

- Afhalen na 1 uur in een winkel met voorraad
- Gratis thuislevering in België vanaf € 30
- Ruim aanbod met 7 miljoen producten
- Afhalen na 1 uur in een winkel met voorraad
- Gratis thuislevering in België vanaf € 30
- Ruim aanbod met 7 miljoen producten
Zoeken
€ 19,45
+ 38 punten
Uitvoering
Omschrijving
Ensure your students get to grips with the core practicals and develop the skills needed to succeed with an in-depth assessment-driven approach that builds and reinforces understanding; clear summaries of practical work with sample questions and answers help to improve exam technique in order to achieve higher grades.
Specificaties
Betrokkenen
- Auteur(s):
- Uitgeverij:
Inhoud
- Aantal bladzijden:
- 104
Eigenschappen
- Productcode (EAN):
- 9781471885167
- Verschijningsdatum:
- 29/04/2017
- Uitvoering:
- Paperback
- Afmetingen:
- 247 mm x 191 mm
- Gewicht:
- 222 g

Alleen bij Standaard Boekhandel
+ 38 punten op je klantenkaart van Standaard Boekhandel
Beoordelingen
We publiceren alleen reviews die voldoen aan de voorwaarden voor reviews. Bekijk onze voorwaarden voor reviews.